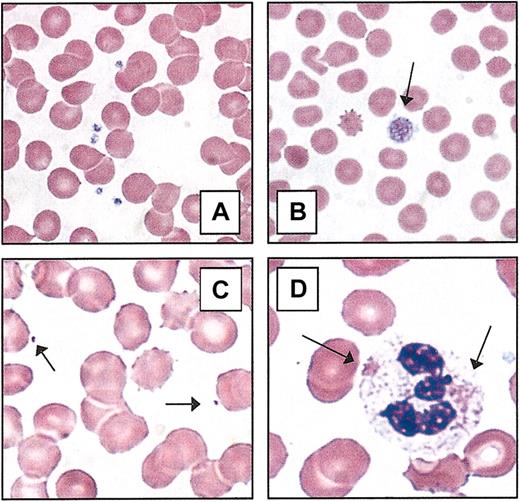
Figure 2. Peripheral blood platelets. (A) Normal blood smear. (B) Macrothrombocyte. The platelet depicted (arrow) is larger than the average erythrocyte. (C) Microthrombocytes (arrows) are typical of those seen in Wiskott-Aldrich syndrome or X-linked thrombocytopenia. (D) Döhle-like bodies in the cytoplasm of neutrophils (arrows) are seen in the May-Hegglin anomaly. All photomicrographs originally made at magnification × 100 (Wright-Giemsa stain).

Abstract
Congenital thrombocytopenias, once considered rare and obscure conditions, are today recognized with increasing frequency, especially due to the measurement of platelet number as part of routine blood testing. The clinical spectrum of congenital thrombocytopenia ranges from severe bleeding diatheses, recognized within the first few weeks of life, to mild conditions that may remain undetected even in adulthood. For the latter group of diseases, distinguishing between inherited (primary) and acquired (secondary) thrombocytopenia, especially immune thrombocytopenia purpura (ITP), is essential to avoid unnecessary and potentially harmful treatments. In this review, the congenital thrombocytopenia syndromes are discussed with specific attention focused on diagnostic criteria, clinical presentations, genetic etiology, and current medical management. The mutated genes responsible for each syndrome are reviewed as well as the potential implications for using gene therapy or gene repair in the future.
Thrombopoiesis
Platelets are small (1-3 μm) anucleate cells that adhere to damaged blood vessels and effect primary hemostasis. Platelets are released by mature megakaryocytes (MKs) and circulate in blood with an average lifespan of 9 days. In adults, approximately 150 billion new platelets are produced each day. Although the “normal” range (150 000-400 000/μL) is quite broad, an individual's platelet count is maintained within a much narrower range.1,2 This requires constant balance of thrombopoiesis with platelet senescence and consumption. The hematopoietic growth factor, thrombopoietin (TPO), is the primary regulator of MK growth and platelet number.3 Unlike erythropoietin (EPO), which is transcriptionally up-regulated in response to hypoxia, TPO is produced primarily in the liver at a constitutive rate.4,5 The plasma TPO level is regulated via adsorption and internalization by cells that express the TPO receptor, Mpl.6 Thus, when platelets and MKs are decreased in number, less TPO is removed from plasma, and the TPO level rises. Conversely, when platelet and MK numbers increase, more TPO is cleared from plasma, and the level falls.
Thrombopoiesis can be depicted as discrete steps along a continuum in which uncommitted stem cells become specialized platelet-producing MKs (Figure 1). First, a pluripotent hematopoietic stem cell undergoes “commitment” through the stochastic or directed induction of megakaryocytic transcription factors, such as GATA-1, FOG-1, FLI-1.7 Second, the committed megakaryoblast becomes a progenitor cell, capable of a finite number of cell divisions. Under the proper culture conditions, megakaryocyte burst-forming units (BFU-MKs, less mature) and megakaryocyte colony-forming units (CFU-MKs, more mature) can give rise to large or small MK colonies, respectively. Third, the CFU-MKs lose the capacity to divide and begin the process of endoreduplication, leading to polyploidization and cellular enlargement. Finally, the immature MK completes its terminal differentiation into a mature MK, with a highly polyploid nucleus (> 16N), expanded size, extensive intracellular organelles for platelet function, and membrane structures for platelet shedding (eg, demarcation membranes and proplatelet processes).
Thrombopoiesis. This drawing depicts the essential developmental stages of a megakaryocyte (MK), from a pluripotent stem cell to a fully differentiated, polyploid, platelet-shedding cell.
Thrombopoiesis. This drawing depicts the essential developmental stages of a megakaryocyte (MK), from a pluripotent stem cell to a fully differentiated, polyploid, platelet-shedding cell.
A large number of genes participate in the differentiation of MKs and the subsequent shedding of platelets, ranging from transcription factors, cytokines, cell surface receptors, and signaling molecules to cytoskeletal proteins, molecular motors, and cell cycle regulators. Mutations in any one of these genes could potentially cause thrombocytopenia due to diminished production or shortened lifespan of platelets. Furthermore, the phenotype may vary depending on the nature and location of the genetic lesion within an individual gene (eg, frameshift, point mutation, deletion, mutation of a critical versus noncritical amino acid) and the roles played by the encoded protein in other tissues. Despite the substantial list of congenital thrombocytopenias discussed in this review, it is likely that many additional rare conditions have yet to be identified. As novel causes of inherited thrombocytopenia are described, the molecular regulation of thrombopoiesis are revealed.
Pseudothrombocytopenia
When an unexpected low platelet count is obtained, artifact or laboratory error should be initially considered. Pseudothrombocytopenia is a relatively common phenomenon caused by platelet aggregation and clumping in the presence of EDTA (ethylenediaminetetraacetic acid) anticoagulant, accounting for 15% to 20% of all patients with isolated thrombocytopenia.8-10 Although most new cell counters are programmed to detect platelet clumps, direct visual inspection of the blood smear is the preferred diagnostic test. An accurate platelet count can usually be achieved by rapid processing of a fresh specimen, collected in citrate buffer. The list of exposures that can cause pseudothrombocytopenia includes cold agglutinins, platelet-specific antibodies, infections, and antibiotics. Particular mention is warranted for the glycoprotein (GP) IIb/IIIa antibody abciximab, which is associated with thrombocytopenia in patients undergoing cardiac revascularization.11-13 It is important to differentiate pseudothrombocytopenia (eg, platelet clumping), from true thrombocytopenia, due to platelet activation and consumption, because pseudothrombocytopenia generally is not associated with bleeding and does not require treatment.
Differentiating inherited (primary) from acquired (secondary) thrombocytopenia
An individual of any age with newly diagnosed thrombocytopenia is more likely to have an acquired disorder rather than an inherited genetic mutation as the underlying etiology. The myriad causes of acquired thrombocytopenia include autoimmune diseases, increased platelet consumption, splenomegaly, marrow suppression (infectious or drug-mediated), and bone marrow failure (Table 1). Depending on the patient's age of onset, the most common causes of acquired thrombocytopenia will vary, reflecting the prevailing diseases for each age range. In newborns, bone marrow suppression due to infection, neonatal alloimmune thrombocytopenia (NAIT), and passive transfer of antibodies from a mother with immune thrombocytopenic purpura (ITP) are the most likely causes of thrombocytopenia.14 In childhood, ITP and acute viral infection are most common. For adults, the differential diagnosis is quite broad, reflecting the increased diversity and prevalence of chronic illnesses and malignancy.
Two important clinical characteristics for recognizing inherited thrombocytopenia syndromes are the age of presentation and the chronicity/duration of symptoms. In the event of severe thrombocytopenia or profound platelet dysfunction, thrombocytopenia is usually recognized during the perinatal period or by the time the child begins to crawl and walk. Milder disorders are noted sporadically throughout life at times of hemostatic stress (eg, onset of menses, surgery/trauma, childbirth). However, a large group of individuals with inherited thrombocytopenia may never have clinically significant bleeding and will be identified during routine blood tests with mild/moderate thrombocytopenia (eg, > 20 000/μL). Although the onset for this latter group may appear to be acute, it is important to obtain previous clinical analyses, ask if there has been a subjective history of easy bruising, prolonged bleeding, or petechiae, and take a careful family history (Table 2). A thorough review of systems may reveal associated conditions that help place thrombocytopenia within a defined clinical syndrome or provide an explanation for secondary thrombocytopenia. Because many of the congenital thrombocytopenias have recognizable changes in platelet morphology, careful examination of the peripheral blood smear should be done for all patients with newly recognized thrombocytopenia. The recognition of giant platelets or microthrombocytes helps to narrow the diagnostic possibilities (Table 3; Figure 2). Furthermore, both very large and very small platelets may be underreported by automated cell counters because of the preset particle size. The presence of abnormal platelet granules, neutrophil inclusions (eg, Döhle bodies), erythroid “teardrop cells,” and hairy cell leukemia are several of the pertinent findings that provide valuable diagnostic information.
Peripheral blood platelets. (A) Normal blood smear. (B) Macrothrombocyte. The platelet depicted (arrow) is larger than the average erythrocyte. (C) Microthrombocytes (arrows) are typical of those seen in Wiskott-Aldrich syndrome or X-linked thrombocytopenia. (D) Döhle-like bodies in the cytoplasm of neutrophils (arrows) are seen in the May-Hegglin anomaly. All photomicrographs originally made at magnification × 100 (Wright-Giemsa stain).
Peripheral blood platelets. (A) Normal blood smear. (B) Macrothrombocyte. The platelet depicted (arrow) is larger than the average erythrocyte. (C) Microthrombocytes (arrows) are typical of those seen in Wiskott-Aldrich syndrome or X-linked thrombocytopenia. (D) Döhle-like bodies in the cytoplasm of neutrophils (arrows) are seen in the May-Hegglin anomaly. All photomicrographs originally made at magnification × 100 (Wright-Giemsa stain).
Categories of congenital thrombocytopenia
Because of the heterogeneity of these syndromes, there are several methods of classification. For example, the congenital thrombocytopenias could be arranged on the basis of clinical features (eg, age at presentation, severity, associated developmental abnormalities). Alternatively, they can be distinguished on the basis of platelet size or by genetic mutation. In this review, the syndromes will be grouped by inheritance pattern (eg, autosomal dominant, autosomal recessive, and X-linked). As a reference tool, Tables 3, 4, and 5 illustrate various strategies for organization.
Autosomal dominant thrombocytopenias
MYH9-related thrombocytopenia syndromes. Syndromes in this category include May-Hegglin anomaly (Online Mendelian Inheritance in Man [OMIM] 155100), Fechtner syndrome (OMIM 153640), Sebastian syndrome (OMIM 605294), Epstein syndrome (OMIM 153650). Familial thrombocytopenia with leukocyte inclusions (May-Hegglin anomaly) has been recognized clinically since 1909.15 Opacities within the cytoplasm of neutrophils appear blue with Wright-Giemsa stain, much like classic Döhle bodies seen during inflammation. However, these Döhle-like inclusions are present chronically, not only during infection or inflammation, and are often larger and more prominent than typical Döhle bodies. Thrombocytopenia is generally mild to moderate, and platelets are enlarged with frequent giant platelets seen on a peripheral blood smear. Automated counters can underestimate the true platelet number because of preset size restriction.
Several variations of autosomal dominant macrothrombocytopenia have been defined based on the presence or absence of neutrophilic inclusions (eg, Döhle-like bodies) and the presence or absence of associated abnormalities similar to Alport syndrome (eg, nephritis, sensorineural hearing loss, and cataracts) as shown in Table 6. These disorders (Fechtner, Sebastian, and Epstein syndromes) have a degree of mild macrothrombocytopenia similar to the May-Hegglin anomaly. The clinical distinction among these disorders has proved difficult, and there may be variable expression of nephritis and hearing loss within a single family or within a single individual at different ages.16 Bleeding tends to be mildly increased in affected individuals, reflecting a nearly normal cumulative platelet mass and largely preserved platelet function.
Etiology. The gene mutated in all 4 of these autosomal dominant macrothrombocytopenias was mapped to the same region, chromosome 22q12-13, and has recently been identified as MYH9, encoding the nonmuscle myosin heavy-chain IIA (NMMHC-IIA).17,18 In addition, mutations of MYH9 have been identified as the likely cause of a form of autosomal dominant nonsyndromic sensorineural deafness (DFNA17; OMIM 603622). The cytoplasmic inclusions in neutrophils consist largely of the mutant NMMHC-IIA protein, which appears to be an important cytoskeletal contractile protein in hematopoietic cells. Macrothrombocytes are probably formed by defective cytoplasmic blebbing of mature MKs. It is likely that a correlation between specific mutations of MYH9 and the expressed phenotype will soon be recognized. However, other genetic and environmental factors are likely to influence the clinical presentation.
Diagnosis/therapy. Macrothrombocytopenia is frequently discovered during routine testing of an asymptomatic individual. In this event, it is important to examine the peripheral blood smear, looking for neutrophilic inclusions and giant platelets. Identification of the precise mutation in MYH9 is an active pursuit by several investigators and will eventually provide important information regarding the structure and function of the protein. In general, affected individuals with mutations of MYH9 do not have life-threatening bleeding events. Affected families should be educated about their diagnosis to avoid unnecessary medications and potentially dangerous treatments for presumed ITP. Platelet transfusion should be effective for bleeding caused by trauma or surgery. There is no known prevention or treatment for the nonhematopoietic consequences of these disorders.
Mediterranean macrothrombocytopenia (OMIM 153670). In Southern Europe, a relatively common and mild form of macrothrombocytopenia has been described.19 Because of the absence of significant bleeding or bruising, affected individuals are usually identified incidentally during routine blood analysis (range, 70 000-150 000 platelets/μL). As in thrombocytopenias caused by mutations of the MYH9 gene, this disorder is associated with large platelet size and largely preserved platelet function, but the degree of thrombocytopenia is less severe.20
Etiology. Linkage analysis of several families localized the gene mutation to the short arm of chromosome 17, and flow cytometry demonstrated impaired expression of the GPIb/IX/V complex (eg, von Willebrand factor receptor) in a high percentage of affected individuals.20 Sequencing of the GPIBA gene identified a mutation of GP1bα (Ala156Val) shared by 10 of 12 pedigrees studied.20 These data demonstrate that for most families with Mediterranean thrombocytopenia, the genotype and phenotype are equivalent to that of a carrier of the Bernard Soulier syndrome (see “Autosomal recessive thrombocytopenias”).
Special conditions: velocardiofacial (OMIM 192430) and DiGeorge syndromes (OMIM 188400). Patients with velocardiofacial (VCF) syndrome and DiGeorge syndrome, marked by cardiac abnormalities, parathyroid and thymus insufficiencies, cognitive/learning impairment, and facial dysmorphology (VCF only), have deletions within human chromosome 22q11 and are collectively referred to by the acronym “CATCH22” (cardiac abnormality, T-cell deficit, cleft palate, hypocalcemia due to Chr22 deletion). Affected individuals are frequently noted to have a mild thrombocytopenia that does not cause significant bleeding. It appears that the platelet disorder is due to deletion of a contiguous gene, GP1BB, in the deleted Chr22q11 locus.21 This condition is analogous to Mediterranean thrombocytopenia, affecting another of the 4 genes that together encode the von Willebrand factor receptor in platelets (GP1BA, GP1BB, GP5, and GP9). It is possible that mutations in one or both of the other 2 genes will be identified causing similar disorders (ie, GP9 and GP5).
Therapy. Individuals with Mediterranean thrombocytopenia and CATCH22 do not need therapy for their mild macrothrombocytopenia. It is important to recognize this condition to avoid unnecessary therapies. Also, married couples who are both carriers of a Bernard-Soulier syndrome (BSS) mutation should receive genetic counseling regarding the risk of having a child with BSS.
Familial platelet disorder with associated myeloid malignancy (OMIM: 601399 FPDMM). In 1996, a large kindred was reported with autosomal dominant thrombocytopenia and a striking predisposition for hematologic malignancy.22 In this family, the degree of thrombocytopenia was mild to moderate, and platelets had normal size and appearance. However, bleeding times were prolonged and an aspirin-like defect in aggregation studies was observed.22 Linkage analysis narrowed the affected gene to an interval on human chromosome 21q22.1-22.2.22
Etiology. The abnormal gene has been identified as AML1, also known as CBFA2 and RUNX1.23 FPDMM has now been associated with either deletion of a single allele (eg, haploinsufficiency) or point mutations of AML1 that abrogate DNA binding of the runt domain.23,24 Evidence suggests that mutated forms of AML-1 that can heterodimerize with PEBP2β/CBFβ in a dominant-negative manner have a higher rate of hematologic malignancy than gene deletion.24 Confirming its role in hematopoiesis, disruption of the cbfa2 gene in mice caused failure of definitive hematopoiesis and lethal hemorrhage during embryonic days 11.5 to 12.5.25 Interestingly, hemizygous deletion of one cbfa2 allele resulted in lower erythroid and myeloid colonies (CFU-MK and platelet counts were not reported).25 Suppression of runx1 in zebrafish results in failure of hematopoiesis as well as angiogenesis, suggesting a critical role for the gene in the hemangioblast.26 It is not clear why, in humans, the heterozygous loss of AML1 function as a transcription factor and tumor suppressor during hematopoiesis should result in a phenotype that is primarily thrombocytopenia.
Special circumstances: related stem cell transplantation in FPDMM. Because of the high incidence of myeloid leukemia at a relatively young age (< 60 years), it is likely that many affected individuals will eventually undergo hematopoietic stem cell transplantation. Unless the clinician is aware of the potential for FPDMM, mild thrombocytopenia in an HLA-matched sibling might be overlooked. There has already been at least one reported case of a transplant from a sibling in which both the donor and recipient subsequently developed donor-derived leukemia.27 If a mutation in AML1 has been identified in a patient with FDP/AML, then potential sibling donors should be screened for this mutation, even if the platelet count is normal.
Autosomal dominant thrombocytopenia with linkage to human chromosome 10 (OMIM 188000, THC2). A novel autosomal dominant thrombocytopenia has been described with genetic linkage to the short arm of chromosome 10, 10p11-12.28,29 Although affected individuals have mild to moderate thrombocytopenia, the residual platelets are normal in size, morphology, and function, based on both clinical history and in vitro aggregation data (J.G.D., unpublished data, July 2002). Mild bleeding symptoms are generally restricted to easy bruising, petechiae, and increased bleeding at times of hemostatic stress (eg, surgery, childbirth). MKs are present in the bone marrow but are small and have hypolobulated nuclei. However, colony-forming assays indicate that MK progenitors are increased.29
The gene mutated in this condition has not been definitively identified. A recent report from our laboratory identified a novel putative kinase, FLJ14813, as a candidate gene, mutated in this disorder.30 Studies are under way to define the role played by this gene in normal and abnormal MK development. The natural history of this disorder suggests that serious hemorrhage is rare and progression to myeloid malignancy is unlikely. Therefore, it is important to recognize the disorder to avoid unnecessary treatment. Understanding the molecular defect responsible for this disorder will elucidate important events that occur during terminal differentiation of MKs.
Paris-Trousseau thrombocytopenia (OMIM 188025). An autosomal dominant macrothrombocytopenia has been associated with deletion of the distal portion of chromosome 11,11q23-24 a region that is also deleted in Jacobsen syndrome (OMIM 147791).31,32 Platelets in this disorder are larger than normal and are characterized by giant α granules (1-2 μm diameter) that appear red by Giemsa stain. Bone marrow shows increased MKs with a predominance of immature micro-MKs. It appears that lysis of maturing MKs occurs spontaneously as a result of the genetic defect.
Mutation of the Ets family transcription factor gene, FLI1, has been implicated as the potential cause of Paris-Trousseau thrombocytopenia because of similarities in the MK abnormalities of mouse embryos in which fli1 has been genetically deleted (eg, immature MKs with hypolobulated nucleus, abnormal α-granule synthesis, and a moderately increased number of small CFU-MK colonies).33,34 Furthermore, the FLI1 gene has been mapped to human chromosome 11q24, the region deleted in Paris-Trousseau thrombocytopenia as well as Jacobsen syndrome (OMIM 147791). It is possible that deletion of a contiguous gene is responsible for the psychomotor retardation and facial and cardiac abnormalities, typical of Jacobsen syndrome.
Gray platelet syndrome (OMIM 139090). Gray platelet syndrome (GPS) is an autosomal dominant macrothrombocytopenia in which the α granules are absent or greatly reduced, giving the platelets a gray color on Wright-Giemsa stain.35,36 The biologic defect does not appear to be synthesis of the α-granule components (von Willebrand factor, adenosine diphosphate [ADP]) but rather in the specific transport and storage of these substances in platelets. Although many pedigrees of GPS clearly demonstrate autosomal dominant inheritance, there are several reports of affected children of healthy parents, indicating that there may be a recessive form of this disorder.37 The affected genes are not currently known.
Autosomal recessive thrombocytopenias
Congenital amegakaryocytic thrombocytopenia (OMIM 604498). A newborn child with severe thrombocytopenia (< 10 000 platelets/μL) and absence of MKs in the bone marrow should raise suspicion for congenital amegakaryocytic thrombocytopenia (CAMT). Because this is a recessive disorder, both parents (carriers) have normal platelet number and function. Affected infants are generally identified within days to weeks of birth because of easy bruising and bleeding. A less severe form of CAMT has been recognized, in which children are born with low platelet number but sufficient to prevent serious bleeding.38 Rather than improving over time, patients with mild CAMT develop worsening thrombocytopenia toward the end of the first decade of life as well as decreased leukocyte and erythrocyte production. Despite optimal supportive care, CAMT leads to pancytopenia by the second decade of life and can be mistaken for other marrow failure syndromes (Fanconi anemia, aplastic anemia, and dyskeratosis congenita).
The differential diagnosis for severe congenital thrombocytopenia includes several inherited genetic disorders in addition to CAMT, most notably thrombocytopenia with absent radii (TAR) and Wiskott-Aldrich syndrome (WAS). Generally, these can be distinguished from CAMT on the basis of associated skeletal hypoplasia of the arms (TAR) and microthrombocytes (WAS), respectively. In addition, antiplatelet antibodies may be transferred from mother to child in utero or at the time of delivery, causing severe thrombocytopenia. Women who lack common platelet antigens may produce antibodies against paternal antigens that are expressed in the developing fetus. This disorder, neonatal alloimmune thrombocytopenia (NAIT), is most frequently due to the maternal absence of an epitope on GPIIIA (PlA1). Finally, mothers who have ITP during pregnancy may transfer antiplatelet antibodies to their children around the time of birth. In contrast to CAMT, both ITP and NAIT resolve over several weeks as the maternal antibodies are cleared and usually demonstrate MKs present in the bone marrow.
Etiology. Several years ago, the molecular etiology for a child with CAMT was identified as composite mutations affecting both alleles of the thrombopoietin receptor, MPL (chromosome 1p34).39 Analysis of additional pedigrees has confirmed that MPL mutations are the primary cause of CAMT.38,40,41 Definitive diagnosis of suspected CAMT is achieved by molecular analysis of the MPL gene. Currently there are at least 15 distinct mutations of MPL described in patients with CAMT located in exons 2, 3, 4, 5, 6, 10, and 12 and a splice-junction mutation of intron 10.38-41
Phenotype-genotype correlation. Although many of these mutations clearly result in a nonfunctional receptor (eg, frameshift or nonsense mutations), others create single amino acid substitutions that must significantly impair normal function. It is likely that the more severe form of CAMT is due to a complete absence of receptor expression or function (MPL–/–), whereas the milder form results from residual activity of a mutant Mpl receptor (MPL–/5%), allowing sufficient platelet production to avoid serious bleeding. However, minimal Mpl function is insufficient to maintain lifelong hematopoietic progenitor production. This disorder illustrates the fact that Mpl signaling is essential for 2 distinct hematopoietic functions: the production of mature MKs and maintenance of the hematopoietic stem cell population.42,43
Treatment of CAMT. The initial treatment of children with CAMT is platelet transfusion sufficient to prevent serious bleeding. Platelet increments and platelet survival should be normal. However, the only long-term treatment for CAMT is hematopoietic stem cell transplantation, which should be undertaken as soon as the diagnosis is secure and an appropriate matched donor has been identified. The genetic etiology of CAMT suggests that this disorder is an excellent candidate for future gene therapy or gene repair. Even a very small percentage of targeted stem cells would be able to proliferate in response to the high endogenous TPO levels and repopulate the bone marrow.
Thrombocytopenia with absent radii (OMIM 274000). TAR syndrome includes shortened or absent forearms due to defects in development of the bilateral radii, associated with severe thrombocytopenia at birth. Skeletal anomalies are also seen in other bones of the arms but do not affect the hands and fingers. Usually, the degree of thrombocytopenia is greatest at the time of birth, and platelet transfusions are frequently required. However, thrombocytopenia becomes less severe during the first year of life, and most affected individuals with TAR will not require platelet transfusions after infancy.44,45
The parents of children with TAR syndrome are completely healthy, and there is no male/female dysequilibrium, indicating an autosomal recessive inheritance pattern. The very low incidence of siblings with TAR suggests that the syndrome may carry an increased risk for fetal demise. There have been several reports of parent-to-child transmission, suggesting an autosomal dominant variant of TAR.46,47
The molecular etiology of TAR remains unknown. Bone marrow from patients with TAR have reduced MK number, and CFU-MKs do not grow in response to TPO.48,49 Although the TPO receptor, Mpl, is present on the cell surface at normal levels, platelets from TAR patients do not undergo increased ADP-induced aggregation in response to TPO nor do they initiate tyrosine phosphorylation of cellular signaling molecules.50 Several laboratories have now demonstrated that mutations of MPL are not present in affected individuals.51,52 From a signal transduction perspective, this suggests that other molecules besides Mpl and Jak2 are necessary to initiate TPO signaling.
The link between osteodysgenesis and thrombocytopenia is unknown but suggests a common mechanism that affects embryonic development of the limbs and megakaryocytopoiesis. The homeobox (HOX) transcription factors have been considered candidate genes for TAR syndrome because of their well-established function in limb development.53 In addition, 2 families were recently reported with radioulnar synostosis and amegakaryocytic thrombocytopenia (OMIM 605432) caused by a mutation of the HOXA11 gene.54,55 However, the inheritance pattern (autosomal dominant), mild deformity of the forearms, and persistence of severe thrombocytopenia all distinguish this condition from TAR syndrome.55 Complete sequencing of the coding regions of HOXA10, HOXA11, and HOXD11 failed to detect any abnormalities in 10 individuals with TAR syndrome.56
Bernard-Soulier syndrome (OMIM 231200). More than 50 years ago Bernard and Soulier recognized an inherited bleeding disorder characterized by lifelong macrothrombocytopenia and marked platelet dysfunction.57 The bleeding tendency exceeds that predicted by the degree of thrombocytopenia. Although parents of affected individuals are unaffected, mild thrombocytopenia may be observed (see “Mediterranean thrombocytopenia”).
Bernard-Soulier syndrome (BSS) is caused by decreased/absent expression of the von Willebrand factor (VWF) receptor on platelets.58 The VWF receptor consists of 4 distinct polypeptide chains: GP1b-α, GP1b-β, GPV, and GPIX. Although mutation of the gene encoding GP1b-α (eg, GP1BA) is most common in BSS, defective GP1b-β or GPIX expression has also been observed.21,47 Despite understanding the molecular pathogenesis of BSS, several questions remain. Why does a defect in the VWF receptor cause macrothrombocytopenia? Does the VWF receptor play a role in thrombopoiesis?
X-linked disorders: Wiskott-Aldrich syndrome and GATA-1 mutations
Wiskott-Aldrich syndrome and X-linked thrombocytopenia (OMIM 301000 and 313900). Wiskott-Aldrich syndrome (WAS), originally described in 1937, affects males almost exclusively and includes moderate to severe thrombocytopenia, immunodeficiency, and eczema (for a review, see Ochs59 ). A milder form exists as X-linked thrombocytopenia (XLT) in which eczema and immunodeficiency are not clinically significant.59 A distinguishing characteristic of these related disorders is the presence of microthrombocytes, with significantly reduced mean platelet volume (MPV 3.5-5.0 fL; normal 7-11 fL) and a stable platelet count of 5000 to 50 000/μL. The combination of reduced platelet size and number results in a combined platelet mass that is about 1% of healthy individuals.
Diagnosis. In any male child with thrombocytopenia or immunodeficiency, the diagnosis of WAS should be considered. The presence of microthrombocytes increases the likelihood of this diagnosis. Affected individuals with classical WAS are generally recognized within 1 year of life due to bruising and bleeding as well as recurrent infections (bacterial more than viral). Diagnosis of patients with XLT may not be made until later in life. Eczema develops after the first year of life, and dermatologic evaluation to assess the severity and treatment of eczema should be undertaken. Confirmatory sequencing of the WAS gene to detect mutations should be performed in families without prior diagnosis. In addition, Western blot or flow cytometry of lymphocytes demonstrates absent/diminished expression of WAS protein. Specialized laboratories can usually detect abnormal lymphocyte proliferation in response to mitogens, HLA, or anti-CD3 antibody as well as impaired class switching from IgM to IgG for classical WAS. In contrast, individuals with XLT may have no defect of lymphocyte function by in vitro testing. Chorionic villus sampling or amniocentesis can also be used to obtain material for prenatal diagnosis when the mother is a known carrier.
Etiology. In 1994, the gene mutated in WAS and XLT (WAS) was identified on the short arm of the X chromosome (Xp11.22).59,60 This gene is composed of 12 exons and encodes a polypeptide of 502 amino acids. The mature WAS protein (WASP) contains numerous protein-interacting domains and appears to provide a critical link between the cellular cytoskeleton and signal transduction pathways. Although it does not encode enzymatic activity, WASP includes subdomains that permit binding to a variety of signaling proteins (SH3-containing proteins, GTPases), membrane phospholipids (Pleckstrin homology domain), polarized cytoskeletal elements (Cofilin and Verprolin domains), and the unique WASP-interacting protein (WIP),61 (for a review, see in Ochs59 ). Interestingly, the development of microthrombocytes, a distinctive feature of the disease, is not well understood, and MKs from patients with WAS are capable of forming proplatelet processes and platelets of normal size in vitro.62 In the bone marrow of affected individuals, MKs appear to be normal or increased in frequency, suggesting a block during thrombopoiesis. Also, the observation that platelet size and number often improves after splenectomy suggests that the reticuloendothelial system could play a role in platelet removal (although antiplatelet antibodies are not present).
Phenotype/genotype correlation. To a large extent, the phenotypic variation of WAS can be explained by the location and nature of the genetic mutation. Frameshifts, nonsense mutations, and large deletions generally cause classical WAS, whereas single amino acid substitutions, especially of exons 1 to 3, cause the milder XLT (for a review, see Ochs59 ). When WASP is completely absent, the disease is more severe; when it is present at low-moderate levels, the disease is frequently milder.
Current therapy. Infections are the most common cause of death in patients with WAS. In the past 4 decades, median life expectancy for patients with severe WAS has been extended from less than 5 years to 10 to 20 years with a significant proportion living into the third and fourth decades of life, largely due to the common use of intravenous γ-globulin (IVIG) and broad-spectrum antibiotics. Thrombocytopenia may cause life-threatening bleeding events. Treatment of acute bleeding is principally platelet transfusions, which provide normal increments and survival of circulating platelets. Splenectomy may induce clinically significant increases in platelet counts but must be considered in the context of an increased risk of sepsis or infection. When eczema is severe, it is treated with topical steroids or short courses of systemic steroids. Individuals over 20 years of age have a markedly increased incidence of autoimmune diseases and lymphomas. In contrast, the milder XLT has a substantially lower risk of these late complications. The only curative therapy remains hematopoietic stem cell transplantation, which corrects both thrombocytopenia and immunodeficiency. For classical WAS, stem cell transplantation should be undertaken for all affected individuals with an appropriate donor.
Special circumstances: girls with Wiskott-Aldrich–like syndromes. Occasionally, girls have been noted to have microthrombocytes with or without other components of the overall syndrome. For at least one patient, the etiology was shown to be spontaneous mutation in one WAS allele coupled with skewed X inactivation among hematopoietic cells.63 However, in other kindreds more than one female has been affected, and no mutation in the WAS gene was detected.64 This suggests that mutation of another gene, perhaps encoding a protein that interacts functionally with the WASP, may cause a similar phenotype.
GATA-1 mutation, a new form of X-linked (macro)thrombocytopenia (OMIM 305371). Recently, 5 pedigrees have been described with an X-linked pattern of thrombocytopenia and mild to moderate dyserythropoiesis.65-69 This disorder can be clinically distinguished from WAS by the presence of large or normal-sized platelets and the absence of immunodeficiency, eczema, and lymphomas. The degree of thrombocytopenia is quite marked (10 000-40 000/μL), whereas the severity of anemia is variable. Clinically, bleeding and bruising in affected individuals are severe, and platelet aggregation studies have shown that platelet function is also diminished.66 The bone marrow appears to be hypercellular with dysplastic features in the erythroid and MK lineages.67 However, there is no evident progression to myelodysplasia, leukemia, or bone marrow failure.
Etiology. For each of these 5 pedigrees, mutations have been detected in the GATA1 gene, a critical transcription factor involved in both MK and erythroid development. The mutations are clustered in the highly conserved N-zinc finger domain, introducing single amino acid substitutions at 4 positions (Val205Met,65 Gly208Ser,67 Arg216Gly,68 Asp218Gly,66 and Asp218Tyr69 ). In 4 of these mutations, the amino acid substitution interferes with the association of GATA-1 with its transcriptional cofactor, FOG-1 (friend of GATA-1). Furthermore, the severity of the thrombocytopenia correlates with the degree to which the GATA-1/FOG-1 interaction is impaired.67,69,70 In contrast, Arg216Gly results in impaired binding of GATA-1 to palindromic DNA-binding sites.68 This mutation also causes a moderate globin chain imbalance (thalassemia).71 Because GATA-1 is critical for erythropoiesis, it is likely that more disruptive changes (eg, nonsense or frameshift mutations) would be lethal. Although one can predict that mutations of the FOG1 gene might have a similar phenotype, families with this disorder have not been identified to date.
Diagnosis. GATA1 mutations should now be suspected in male children with severe thrombocytopenia, normal to large platelets, and absence of immunodeficiency and eczema. Erythroid dysmorphology, mild anemia, and hypercellular bone marrow are all consistent with the diagnosis. Sequencing the GATA1 gene is the only confirmatory test and is only available through specialized laboratories.
Therapy. Individuals with GATA1 mutations respond well to therapeutic platelet transfusions. These should be limited to treatment of persistent bleeding and trauma/surgical challenge because of the risk of alloimmunization. If anemia/thrombocytopenia are life threatening, stem cell transplantation is curative.65 Repair of the GATA1 mutation or addition of a normal GATA1 gene to autologous hematopoietic stem cells offers an alternative future therapy.
Diagnostic testing
Despite careful clinical analysis, a substantial number of individuals will not fit into any of the disorders described. For these individuals, referral to a hematologist who specializes in inherited platelet disorders may be reasonable. Bone marrow aspirate and biopsy should be performed to identify the number and morphology of megakaryocytes. MK colony assays are helpful for identifying the frequency of MK precursors as well as evidence of maturation arrest. Platelet function analysis and aggregation studies may require concentration to achieve a final platelet count more than 100 000/μL. Recently, the combination of in vitro megakaryocytopoiesis and plasma levels of TPO and glycocalicin (eg, soluble GP1b) has been shown to be an effective method for distinguishing between several forms of inherited thrombocytopenia.72 In some cases, a therapeutic trial may be necessary to better understand the disorder. This may take the form of transfusion to test platelet survival, steroids, or IVIG. Splenectomy should be reserved for those individuals with severe inherited thrombocytopenia and no option for stem cell transplantation.
Future directions
Once considered a rarity, the inherited thrombocytopenia syndromes are increasingly recognized as a spectrum of clinical disorders, ranging from severe diseases in neonates to mild conditions that are identified incidentally in adults. With a better understanding of pathogenesis, the focus can turn toward more rational therapies, including the use of TPO to stimulate platelet production in mild/moderate disorders and gene replacement or gene repair in the severe diseases.
Prepublished online as Blood First Edition Paper, September 22, 2003; DOI 10.1182/blood-2003-05-1742.